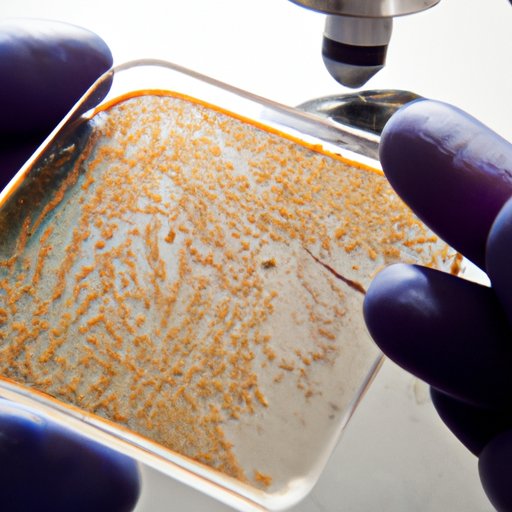

Introduction
Microbiology is a field of science that studies the structure, function, and behavior of microscopic organisms, including bacteria, viruses, protozoa, and fungi. By understanding these tiny organisms, microbiologists are able to make significant contributions to science that have a profound impact on society.
What are Microbes?
Microbes are tiny organisms that are too small to be seen with the naked eye. These organisms can exist in various environments, including soil, water, and air, and play an important role in the planet’s ecosystems. Although they are often associated with disease, most microbes are harmless and many are even beneficial to humans.
Importance of Understanding Microbes
By studying microbes, microbiologists are able to gain insight into how organisms interact with each other and their environment. This knowledge can then be used to develop treatments for diseases and create new technologies for industrial and environmental applications. The importance of microbiologists’ contributions to science cannot be understated.

Exploring the Role of Microbes in Human Health and Disease
Microorganisms play an important role in human health and disease. While some microbes can cause illness, others can help prevent it. By understanding the relationship between microbes and human health, researchers can develop treatments for infectious diseases and improve public health.
Microorganisms and Pathogenic Diseases
Certain microorganisms can cause serious illnesses, such as tuberculosis, cholera, and malaria. In order to protect people from these diseases, scientists must understand how the microorganisms spread and what treatments are effective against them. With this knowledge, researchers can develop vaccines and treatments to prevent or treat these illnesses.
Understanding the Role of Microbes in Infectious Diseases
Infectious diseases are caused by microorganisms that invade the body and cause symptoms such as fever, rash, and fatigue. By studying these pathogens, researchers can identify the factors that allow them to spread and develop treatments to combat them. For example, researchers have identified the genes responsible for antibiotic resistance in certain bacteria, which has helped them develop more effective treatments for infections.
Examining the Effects of Antibiotic Resistance on Public Health
Antibiotic resistance occurs when bacteria become resistant to antibiotics, making it difficult to treat infections. This is an increasing problem in public health, as more and more bacteria become resistant to commonly used antibiotics. By studying the mechanisms of antibiotic resistance, scientists can develop new strategies to combat this growing problem.
Overview of Antibiotic Resistance
Antibiotic resistance occurs when bacteria become resistant to antibiotics due to genetic mutations. This can occur naturally over time or as a result of inappropriate use of antibiotics. As bacteria become increasingly resistant to antibiotics, it becomes harder to treat infections caused by these organisms.
Impact of Antibiotic Resistance on Public Health
The effects of antibiotic resistance on public health are far-reaching. Not only does it make it difficult to treat infections, but it also increases healthcare costs and puts people at risk of developing life-threatening illnesses. According to the Centers for Disease Control and Prevention (CDC), antibiotic resistance is one of the biggest public health challenges of our time.
Investigating the Benefits of Probiotics on Gut Health
Probiotics are live microorganisms that can help maintain a healthy gut. By understanding how these microorganisms affect the body, scientists can develop treatments to improve gut health and reduce the risk of digestive disorders.
What are Probiotics?
Probiotics are live microorganisms that are found in certain foods and supplements. They can help maintain a healthy balance of bacteria in the gut, which can improve digestion and boost the immune system.

Benefits of Probiotics on Gut Health
Studies have shown that probiotics can help reduce inflammation in the gut, improve digestion, and reduce the risk of digestive disorders. In addition, probiotics have been shown to help reduce the symptoms of irritable bowel syndrome and other gastrointestinal conditions. Furthermore, research has suggested that probiotics may help reduce the risk of certain cancers.
Uncovering New Uses for Microbes in Industrial Applications
Microbes can also be used in industrial applications to produce products such as food, fuel, and pharmaceuticals. By understanding the properties of microbes, scientists can develop new processes and technologies to create these products more efficiently.
Overview of Industrial Microbiology
Industrial microbiology is the study of microbes and their application in industrial processes. This field of science has a wide range of applications, from creating new drugs to producing food and fuel. By understanding the properties of microbes, researchers can develop new processes and technologies to create products more efficiently.

Examples of Industrial Applications of Microbes
Microbes are used in a variety of industrial applications, such as producing food, fuel, and pharmaceuticals. For example, yeast is used to ferment sugar into alcohol, while bacteria are used to break down organic matter into useful fertilizers. Additionally, microbes can be used to produce enzymes and antibiotics, which are used in the production of medicines and other products.
Analyzing the Impact of Microbes on the Environment
Microbes play an important role in the environment by breaking down organic matter and releasing nutrients into the soil. By studying the interactions between microbes and their environment, scientists can better understand the effects of climate change and pollution on the planet.
Overview of Environmental Microbiology
Environmental microbiology is a field of science that studies the interactions between microbes and their environment. By understanding these interactions, researchers can identify ways to mitigate the effects of climate change and other environmental issues.
Effects of Microbes on the Environment
Microbes play an important role in the environment by breaking down organic matter and releasing nutrients into the soil. In addition, they are essential for the cycling of nutrients and carbon, which helps maintain a healthy ecosystem. Furthermore, microbes can be used to clean up polluted areas, such as oil spills, and can help reduce the amount of waste produced.
Conclusion
Microbiology is a field of science that studies the structure, function, and behavior of microscopic organisms. By understanding these organisms, microbiologists are able to make significant contributions to science that have a profound impact on society. Their work has enabled us to better understand and treat infectious diseases, develop antibiotics, create new industrial processes, and protect the environment.
The importance of microbiologists’ contributions to science cannot be overstated. By continuing to explore the roles of microbes in human health and the environment, scientists will be able to further improve public health and create new technologies for industrial and environmental applications.
(Note: Is this article not meeting your expectations? Do you have knowledge or insights to share? Unlock new opportunities and expand your reach by joining our authors team. Click Registration to join us and share your expertise with our readers.)